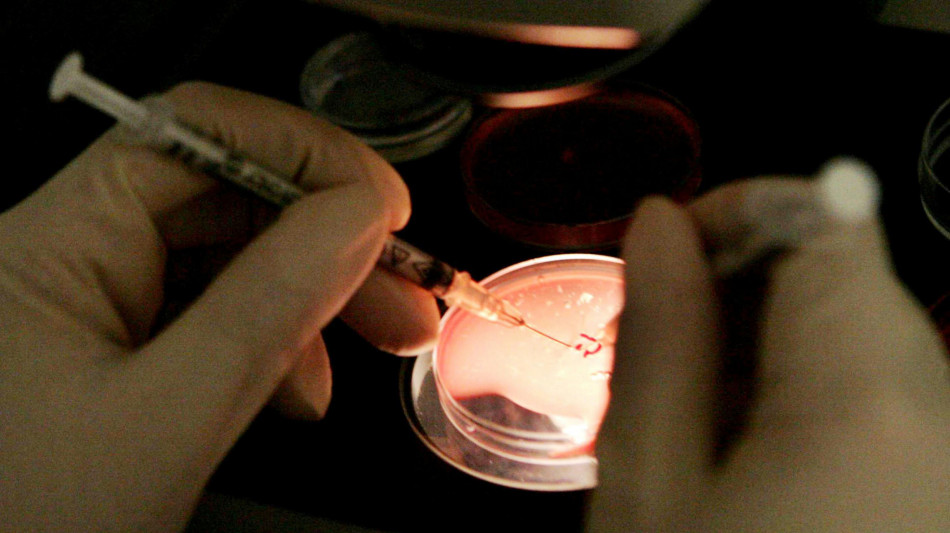
Media, 200 bebè nati in Europa da un donatore di sperma a rischio cancro

-
 Tennis: a Miami piove, sospesa la finale di doppio donne con Errani/Paolini
Tennis: a Miami piove, sospesa la finale di doppio donne con Errani/Paolini
-
Kast blocca l'espropriazione di un centro di tortura di Pinochet

-
 Euro U21: Palmisani 'siamo sul pezzo, pronti per la Svezia'
Euro U21: Palmisani 'siamo sul pezzo, pronti per la Svezia'
-
Calcio: Da Chicago a Zenica per tifare Bosnia, 'ma sarà dura'

-
 Calcio: allenamento azzurri, Gattuso verso la conferma di Retegui
Calcio: allenamento azzurri, Gattuso verso la conferma di Retegui
-
Cosmoprof 2026 chiude, in mostra oltre 10.000 marchi beauty per una edizione da record

-
 Libano, 'oltre 1.200 morti nei raid israeliani dall'inizio della guerra'
Libano, 'oltre 1.200 morti nei raid israeliani dall'inizio della guerra'
-
Aiuti a Cuba, arrivano anche 30 mila tonnellate di riso dalla Cina

-
 Il Venezuela riapre le sue missioni diplomatiche negli Usa
Il Venezuela riapre le sue missioni diplomatiche negli Usa
-
Teheran, 'aspettiamo l'arrivo delle truppe Usa per dar loro fuoco'

-
 Netanyahu ordina all'Idf di ampliare ancora la zona cuscinetto in Libano
Netanyahu ordina all'Idf di ampliare ancora la zona cuscinetto in Libano
-
Herzog telefona a Pizzaballa, 'profondo dolore per l'ncidente'

-
 Kiev, '3 civili uccisi tra cui un ragazzo in un attacco russo su Kramatorsk'
Kiev, '3 civili uccisi tra cui un ragazzo in un attacco russo su Kramatorsk'
-
Tv Al Araby, '10 feriti in attacco alla sede di Teheran, è inaccettabile'

-
 'Roma, semplicemente Roma', dal calcio di strada alla Curva Sud
'Roma, semplicemente Roma', dal calcio di strada alla Curva Sud
-
Polizia Israele, 'la richiesta del Patriarca respinta per ragioni di sicurezza'

-
 Professione parrucchiere, regole in arrivo e giovani talenti al Cosmoprof
Professione parrucchiere, regole in arrivo e giovani talenti al Cosmoprof
-
Premier: Tudor via dal Tottenham, risoluzione consensuale

-
 Lingerie e libertà, la maison Chantelle compie 150 anni
Lingerie e libertà, la maison Chantelle compie 150 anni
-
Atletica: Andy Diaz, al Golden Gala voglio fare il record del mondo

-
 Sci nordico: l'ultima da professionista di Pellegrino, ora una nuova vita
Sci nordico: l'ultima da professionista di Pellegrino, ora una nuova vita
-
Amb. Israele, avremmo preferito una risposta differente dall'Italia ma capiamo

-
 Will Arnett, Laura Dern e la comicità come terapia di coppia
Will Arnett, Laura Dern e la comicità come terapia di coppia
-
I 20 anni swing e vintage di Puppini Sisters, anche Re Carlo tra i fan

-
 Vingegaard vince il Giro di Catalogna, ultima tappa a Gilmore
Vingegaard vince il Giro di Catalogna, ultima tappa a Gilmore
-
Macron condanna la decisione della polizia israeliana di fermare Pizzaballa

-
 Aspides, 'tornano gli Houthi, massima cautela in Mar Rosso e Golfo Aden'
Aspides, 'tornano gli Houthi, massima cautela in Mar Rosso e Golfo Aden'
-
Mps, sostenere lista Cda per garantire stabilità, continuità e governance

-
 Bankitalia nomina due commissari per affiancare cda Bff
Bankitalia nomina due commissari per affiancare cda Bff
-
Cdm skicross, Deromedis vince l'ultima gara stagionale

-
 Azzurri: Politano "Mondiali l'unico pensiero, con Bosnia serve partire forte"
Azzurri: Politano "Mondiali l'unico pensiero, con Bosnia serve partire forte"
-
Tim disdice il contratto aziendale con Inwit

-
 Antonelli, dall'aereo tiferò Sinner e gli italiani in MotoGp
Antonelli, dall'aereo tiferò Sinner e gli italiani in MotoGp
-
Tajani, inaccettabile il divieto a Piazzaballa, Italia esprime sdegno

-
 Portofino Awards, premiato Romano Reggiani
Portofino Awards, premiato Romano Reggiani
-
A Cortinametraggio il miglior corto è Bratiska

-
 Bocelli si racconta, 'la musica mi ha aiutato a far bella la mia vita'
Bocelli si racconta, 'la musica mi ha aiutato a far bella la mia vita'
-
Mondiali: il francese Turpin arbitrerà l'Italia in Bosnia

-
 Giorgia, 'gli stadi? Mai avuto questa ambizione, sono più da club'
Giorgia, 'gli stadi? Mai avuto questa ambizione, sono più da club'
-
Bambole di Pezza, la nostra musica suonata tra rock, identità e denuncia

-
 'Cinque morti e quattro feriti in attacco a città portuale sul Golfo Persico'
'Cinque morti e quattro feriti in attacco a città portuale sul Golfo Persico'
-
Presidente Aci "Antonelli come Ascari nel 1952, fa la storia"

-
 Antonelli vince anche in Giappone, è il leader del mondiale
Antonelli vince anche in Giappone, è il leader del mondiale
-
Nba: Wembanyama spinge gli Spurs, Doncic squalificato

-
 Usa battuti 5-2 dal Belgio a due mesi e mezzo dal Mondiale
Usa battuti 5-2 dal Belgio a due mesi e mezzo dal Mondiale
-
Dopo Indian Wells, Sabalenka vince anche Miami

-
 MotoGP: Austin, Martin vince la Sprint Race
MotoGP: Austin, Martin vince la Sprint Race
-
Springsteen alla manifestazione No King, 'il Minnesota è un'ispirazione'

-
 Intercettati due droni contro l'ambasciata Usa a Baghdad
Intercettati due droni contro l'ambasciata Usa a Baghdad
-
Media, ucciso in un raid scienziato iraniano responsabile programma nucleare

Media, 200 bebè nati in Europa da un donatore di sperma a rischio cancro
Il caso denunciato in Danimarca. Ad alcuni piccoli è stato poi diagnosticato il male
Lo sperma di un singolo donatore afflitto da una grave mutazione genetica, tale da accrescere enormemente il rischio di cancro, è stato commercializzato in Danimarca da una nota banca del seme contribuendo ad aiutare coppie sterili o in difficoltà a far nascere negli ultimi mesi in giro per l'Europa quasi 200 bambini grazie alla fecondazione assistita. Lo ha rivelato un'inchiesta giornalistica condotta da 14 emittenti televisive europee di altrettanti Paesi fra cui la britannica Bbc. Stando all'inchiesta, il numero registrato di bebè concepiti con il seme di questo donatore - inconsapevole, a quanto pare - ammonta esattamente a 197. E alcuni piccoli risultano essere nel frattempo già morti. La Bbc cita esperti secondo i quali la mutazione genetica in questione, rilevata tardivamente, è destinata a far sì che solo una minoranza dei bambini coinvolti possa sperare di non essere affetta da patologie oncologiche vita natural durante. Precisa inoltre che la banca danese non ha veduto lo sperma contaminato ad alcuna clinica d'oltre Manica, non avendo rapporti di partnership nel Regno Unito, ma che comunque "un piccolissimo numero" di coppie britanniche, impegnate attualmente in trattamenti contro l'infertilità in Danimarca, è stato messo in allerta dalle autorità. I responsabili della banca del seme danese, la Denmark's European Sperm Bank, hanno, da parte loro, ammesso l'accaduto, insistendo nell'affermare che il donatore era "ignaro" al momento della donazione. Nel contempo hanno espresso "profonda compassione" verso le famiglie coinvolte, non senza riconoscere come i campioni venduti all'estero possano essere stati usati per generare "troppi bambini" in alcuni Paesi imprecisati.
E.Aziz--SF-PST




